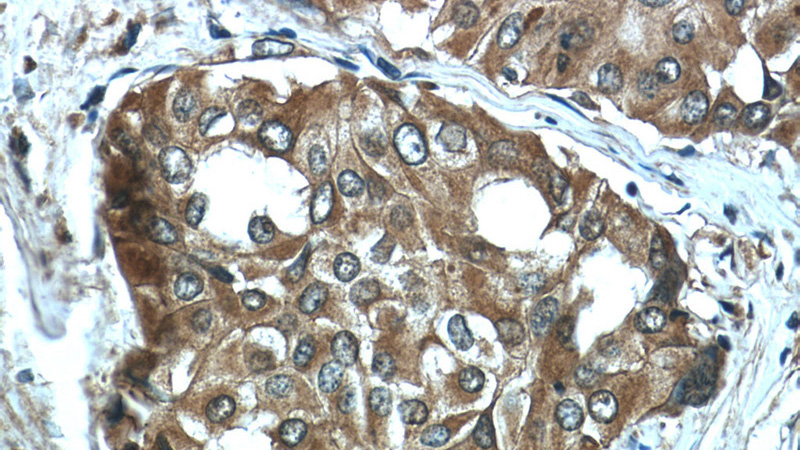
Immunohistochemistry of paraffin-embedded human thyroid cancer tissue slide using Catalog No:115496(SLC5A5 Antibody) at dilution of 1:50 (under 40x lens)

-
Product Name
Sodium iodide symporter antibody
- Documents
-
Description
Sodium iodide symporter Rabbit Polyclonal antibody. Positive IP detected in mouse testis tissue. Positive WB detected in mouse testis tissue, mouse stomach tissue, SGC-7901 cells. Positive IHC detected in human thyroid cancer tissue, human ovary tissue. Positive FC detected in MCF-7 cells. Observed molecular weight by Western-blot: 50-55, 75-100 kDa
-
Tested applications
ELISA, WB, FC, IHC, IP
-
Species reactivity
Human, Mouse, Rat; other species not tested.
-
Alternative names
NIS antibody; SLC5A5 antibody; Sodium iodide symporter antibody; Sodium/iodide cotransporter antibody
-
Isotype
Rabbit IgG
-
Preparation
This antibody was obtained by immunization of Sodium iodide symporter recombinant protein (Accession Number: NM_000453). Purification method: Antigen affinity purified.
-
Clonality
Polyclonal
-
Formulation
PBS with 0.1% sodium azide and 50% glycerol pH 7.3.
-
Storage instructions
Store at -20℃. DO NOT ALIQUOT
-
Applications
Recommended Dilution:
WB: 1:200-1:2000
IP: 1:200-1:2000
IHC: 1:20-1:200
-
Validations

mouse testis tissue were subjected to SDS PAGE followed by western blot with Catalog No:115496(SLC5A5 Antibody) at dilution of 1:600
Immunohistochemistry of paraffin-embedded human thyroid cancer tissue slide using Catalog No:115496(SLC5A5 Antibody) at dilution of 1:50 (under 40x lens)

1X10^6 MCF-7 cells were stained with 0.2ug SLC5A5 antibody (Catalog No:115496, red) and control antibody (blue). Fixed with 90% MeOH blocked with 3% BSA (30 min). Alexa Fluor 488-congugated AffiniPure Goat Anti-Rabbit IgG(H+L) with dilution 1:100.

IP Result of anti-SLC5A5 (IP:Catalog No:115496, 4ug; Detection:Catalog No:115496 1:500) with mouse testis tissue lysate 4000ug.

Immunohistochemistry of paraffin-embedded human thyroid cancer tissue slide using Catalog No:115496(SLC5A5 Antibody) at dilution of 1:50 (under 10x lens)
-
Background
The sodium iodide symporter (Na+/I - symporter, NIS), encoded by SLC5A5, is an integral plasma membrane glycoprotein that plays an important role in iodide uptake by thyroid cells. Expression of sodium iodide symporter has also been found in extra-thyroidal tissues, including gastric mucosa, lactating mammary gland and salivary glands. Increased expression of sodium iodide symporter has been found in thyroid tissue from patients with Graves’ disease as well as papillary thyroid carcinomas. In addition, sodium iodide symporter was found to express in majority of breast cancer tissue but not in normal tissue. Sodium iodide symporter can be a promising diagnostic and therapeutic tool for thyroid cancer and breast cancer. This antibody recognizes the mature approximately 75-100 kDa protein and a partially glycosylated 50-55 kDa protein. (12588808, 9525971)
-
References
- Shi S, Zhang M, Guo R. Feasibility of lentiviral‑mediated sodium iodide symporter gene delivery for the efficient monitoring of bone marrow‑derived mesenchymal stem cell transplantation and survival. International journal of molecular medicine. 34(6):1547-54. 2014.
- Shi S, Zhang M, Guo R. In vivo molecular imaging and radionuclide (131I) therapy of human nasopharyngeal carcinoma cells transfected with a lentivirus expressing sodium iodide symporter. PloS one. 10(1):e0116531. 2015.
- Ruan M, Liu M, Dong Q, Chen L. Iodide- and glucose-handling gene expression regulated by sorafenib or cabozantinib in papillary thyroid cancer. The Journal of clinical endocrinology and metabolism. 100(5):1771-9. 2015.
- Xu B, Yang H, Sun M. 2,3',4,4',5-Pentachlorobiphenyl Induces Inflammatory Responses in the Thyroid Through JNK and Aryl Hydrocarbon Receptor-Mediated Pathway. Toxicological sciences : an official journal of the Society of Toxicology. 149(2):300-11. 2016.
Related Products / Services
Please note: All products are "FOR RESEARCH USE ONLY AND ARE NOT INTENDED FOR DIAGNOSTIC OR THERAPEUTIC USE"
